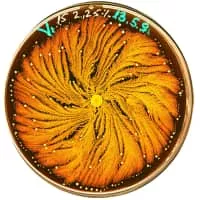
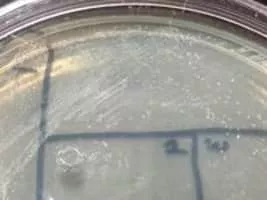

Paenibacillus
| Use attributes for filter ! | |
| Scientific name | Paenibacillus |
|---|---|
| Order | Bacillales |
| Rank | Genus |
| Division | Firmicutes |
| Higher classification | Paenibacillaceae |
| Class | Bacilli |
| Date of Reg. | |
| Date of Upd. | |
| ID | 2417062 |
About Paenibacillus
Paenibacillus is a genus of facultative anaerobic, endospore-forming bacteria, originally included within the genus Bacillus and then reclassified as a separate genus in 1993.